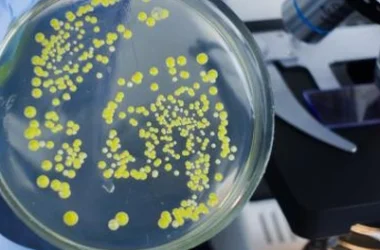

فهرس المحتويات
| المقطع | العنوان |
|---|---|
| مقدمة في عالم الغزلان | مقدمة في عالم الغزلان |
| الغزال المرقط | الغزال المرقط |
| غزال المستنقع | غزال باراسينغا (غزال المستنقع) |
| غزال باوان | غزال باوان |
| المنجتق البورنيوي الأصفر | المنجتق البورنيوي الأصفر |
| غزال بروكيت | غزال بروكيت |
| غزال كالاميان | غزال كالاميان |
| غزال الماء الصيني | غزال الماء الصيني |
| غزال إلد | غزال إلد |
| غزال فالو | غزال فالو |
| خاتمة | خاتمة |
رحلة إلى عالم الغزلان
تُشكل الغزلان عائلةً واسعةً من الثدييات ذات الحوافر، وتتميز بقرونها المتجددة. تُظهر هذه الحيوانات نشاطًا ملحوظًا خلال ساعات الفجر والغسق. سنستعرض في هذا المقال تنوعًا مذهلاً في أنواع الغزلان، موضحين خصائص كل نوع، وبيئته، وحالته الحالية.
جمال الغزال المرقط
يُعرف الغزال المرقط (Axis Deer) بقدرته على التكيّف مع بيئات مختلفة، إلا أن موطنه الأصلي يقع في الهند، نيبال، سريلانكا، بوتان، وبنغلاديش. يبلغ طول جسمه حوالي 1.1-1.4 متر، ويصل وزن الذكور إلى 91 كغ والإناث إلى 75 كغ تقريبًا. تتميز الذكور بلونها الداكن مقارنةً بالإناث، وتُظهر النقاط البيضاء المنتشرة على جسمها، بالإضافة إلى أطرافها السفلية البيضاء ورموشها الطويلة، جمالاً خلاباً. يصل طول قرون ذكور الغزال المرقط إلى 76 سم.
غزال المستنقعات
يُطلق على غزال باراسينغا (Barasingha Deer) اسم “غزال المستنقع” نسبةً إلى بيئته المفضلة. أصل اسمه يعود إلى اللغة الهندية، ويعني “اثنا عشر طرفًا”، إشارة إلى عدد تشعّبات قرونه التي تتراوح عادةً بين 12 و 20. ينتشر هذا النوع في المناطق الشمالية والوسطى من الهند، وجنوب غرب نيبال. يبلغ طول جسمه 1.8 متر، ولون معطفه بني فاتح في الصيف، ويصبح بني داكن في الشتاء. يعيش غزال باراسينغا في مجموعات خلال فصل الشتاء، بينما تنفصل الذكور عن القطيع في فصل الصيف.
غزال جزيرة باوان
يُعدّ غزال باوان (Bawean Deer) من الأنواع المهددة بالانقراض، ويوجد فقط في جزيرة باوان الإندونيسية. يشبه غزال الخنزير الهندي، لكن رأسه أصغر وأرجله أقصر. يمتلك معطفًا بنيًا مع علامات بيضاء أسفل الذقن والحلق، وأسفل ذيله الطويل. عادةً ما تمتلك قرونه ثلاث شوكات. تتميز غزلان باوان بخجلها، وعادتها في العيش منفردة، ونشاطها الليلي.
المنجتق الأصفر من بورنيو
يعيش المنجتق البورنيوي الأصفر (Bornean Yellow Muntjac) في غابات بورنيو المطيرة في جنوب شرق آسيا. يمتلك معطفًا بني مصفر وأطرافًا بيضاء. قرون ذكوره قصيرة، لا يتجاوز طولها 5 سم. تفتقر الأبحاث لدراسة هذا النوع إلى المعلومات الكافية، ولكن يُعتقد أنه يفضل العيش منفردًا أو مع شريكه، ويستخدم صوته للتحذير من الخطر. يبلغ طول جسمه بين 0.9 و 1 متر، ويصل وزنه إلى 13-18 كغ.
غزال بروكيت المتنوع
يضمّ جنس غزال بروكيت (Brocket Deer) حوالي 10 أنواع، تعيش في مناطق ذات غطاء نباتي كثيف. تنتشر في شبه جزيرة يوكاتان، وأمريكا الجنوبية والوسطى، وجزيرة ترينيداد. أحجامها صغيرة إلى متوسطة، ويتراوح طولها بين 0.7 و 1.4 سم، ووزنها بين 8 و 30 كغ. تتميز بقرونها القصيرة، وفترات طويلة بين استبدالها. ومن أشهر أنواعها الشادن الأحمر، الشادن الرمادي، الشادن القزم، والشادن الصغير.
غزال كالاميان المهدد
يُعرف غزال كالاميان (Calamian Deer) بانتشاره في جزر كالاميان غرب الفلبين. يُعاني من الصيد الجائر، وإزالته من بيئته الطبيعية، مما يجعله مهددًا بالانقراض. يُفضل العيش في الغابات، بالقرب من المستنقعات والأنهار. يبلغ طول جسمه حوالي 1 متر، وزنه بين 36 و 50 كغ. يمتلك ذكور هذا النوع قرونًا بثلاث شوكيات، يصل طولها إلى 23 سم تقريبًا. يعيش في قطعان صغيرة لا تتجاوز 14 فردًا.
غزال الماء الصيني الفريد
يتميز غزال الماء الصيني (Chinese Water Deer) بمعطفه البني المحمر الذي يتحول إلى رمادي فاتح في الشتاء. يوجد في الصين وكوريا، وانتشر مؤخرًا في بريطانيا. يُفضل المناطق المفتوحة، والغنية بالأعشاب، وعند المستنقعات وضفاف الأنهار. يختلف عن غيره من الغزلان بعدم امتلاك ذكوره قرونًا، لكنه يمتلك أنيابًا بارزة طويلة. ذيله قصير ووجهه يشبه وجه الدببة الصغيرة. يبلغ طول جسمه بين 0.7 و 1 متر.
غزال إلد الرائع
يُعتبر غزال إلد (Eld’s Deer) من الغزلان الجميلة والمهددة بالانقراض. موطنه الأصلي جنوب آسيا، ويُفضل الأماكن المفتوحة، والغابات الخفيفة، والقرب من المستنقعات والأراضي الرطبة والأنهار. يُظهر معطفه لونًا بني محمرًا، يصبح داكنًا في الشتاء. يصل طول قرونه إلى مترين، مع 12 تشعبًا تقريبًا. يتراوح طول جسمه بين 1.5 و 1.8 متر، ويصل وزنه إلى 150 كغ.
غزال فالو ذو المعطف المرقّط
يُعرف غزال فالو (Fallow Deer) بمعطفه المرقّط وجماله. يعيش في قطيع صغير في الغابات ذات الأوراق المتساقطة أو المختلطة. موطنه الأصلي آسيا، ولكنه انتشر حاليًا في إنجلترا، وويلز، وأيرلندا، وجنوب اسكتلندا. ألوانه متعددة، معظمها بني مع بقع بيضاء. يتراوح طول جسمه بين 1.3 و 1.8 سم، وزنه بين 31 و 63 كغ. موسم تكاثره في الخريف.
Add more deer types here
ختامًا
يُظهر هذا العرض الموجز لبعض أنواع الغزلان تنوعًا مذهلاً في الأشكال والأحجام والبيئات. يُبرز أيضًا أهمية حماية هذه الأنواع من التهديدات التي تواجهها، كالصيد الجائر وفقدان مواطنها الطبيعية، لضمان بقائها للأجيال القادمة.